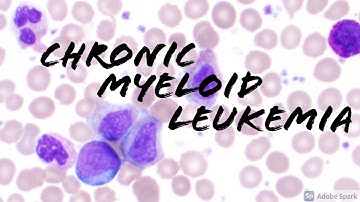
Chronic Myeloid Leukemia (CML) Peripheral Blood Smear (Hematopathology & Hematology)

⬇ DOWNLOAD NOW
Kalau muncul iklan pop-up, tutup lalu klik tombol kembali
Download lagu ]N[ vs every CML in a Reaver secara gratis hanya untuk keperluan promosi. Dukung artis favorit kamu dengan membeli musik original di iTunes atau platform resmi lainnya.
 Which Reaver Vandal Skin is the BEST?
Which Reaver Vandal Skin is the BEST?
 Reaver or Prime?
Reaver or Prime?
 Prime Vandal or Reaver Vandal???
Prime Vandal or Reaver Vandal???
 Reaver VS Prime in VALORANT
Reaver VS Prime in VALORANT
 Chronic Leukemias - CML and CLL - Hematology / Oncology
Chronic Leukemias - CML and CLL - Hematology / Oncology
Chronic Myeloid Leukemia (CML) Peripheral Blood Smear (Hematopathology & Hematology)
Chronic Myeloid Leukemia (CML) Peripheral Blood Smear (Hematopathology & Hematology)
 Chronic Leukemia | Clinical Medicine
Chronic Leukemia | Clinical Medicine
 Reaver 2.0 IS A SCAM! #shorts
Reaver 2.0 IS A SCAM! #shorts